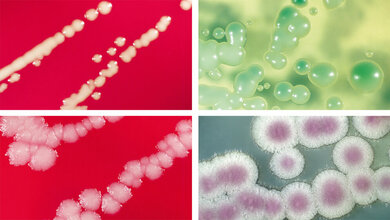
Die Rolle der Sprosspilze in der Medizin (Teil II)

Zusammenfassung
Die klinische Wirksamkeit von Antimykotika ist im Vergleich zu der zuverlässigen Wirkung von Antibiotika geringer. Die Bestimmung der Wirkspiegel im Blut – also ein Therapeutisches Drug Monitoring (TDM) – kann eventuell helfen, die Dosierung zu steuern und damit die Therapieerfolge von Antimykotika zu optimieren. Dabei geht es darum, einerseits eine Unterdosierung zu erkennen, weil bei zu niedrigen Spiegeln die antimikrobielle Wirkung nicht voll erreicht wird, und andererseits eine Überdosierung zu verhindern, um toxische Nebenwirkungen zu vermeiden. Die Wirkspiegel können nämlich durch verschiedene, individuelle Umstände von Patient zu Patient variieren. Vor allem bei Einsatz von Itraconazol und Voriconazol ist ein TDM anzuraten. Verschiedene Labortechniken, wie HPLC-UV oder LC-MSMS, kommen dabei zum Einsatz.
Schlüsselwörter: Therapeutisches Drug Monitoring, TDM, Antimykotika, Itraconazol, Voriconazol
Abstract
The clinical efficiency of antimycotics is relatively lower than that of antibiotics. The determination of drug levels in blood, i.e. a therapeutic drug monitoring (TDM), can help to control the dosage and hence to optimize the therapeutic efficiency of antimycotics. At first, insufficient doses resulting in concentrations too low for optimal antimicrobial activity should be recognized. Second, overdosing should be avoided, because this could trigger toxic side effects. The drug levels can definitely vary from one patient to another due to certain individual circumstances. TDM is indicated in particular during use of itraconazole and voriconazole. Various laboratory techniques such as HPLC-UV or LC-MSMS are applied.
Keywords: therapeutic drug monitoring, TDM, antimycotics, itraconazole, voriconazole
DOI: 10.3238/MTADIALOG.2021.0519
Entnommen aus MTA Dialog 7/2021
Dann nutzen Sie jetzt unser Probe-Abonnement mit 3 Ausgaben zum Kennenlernpreis von € 19,90.
Jetzt Abonnent werden